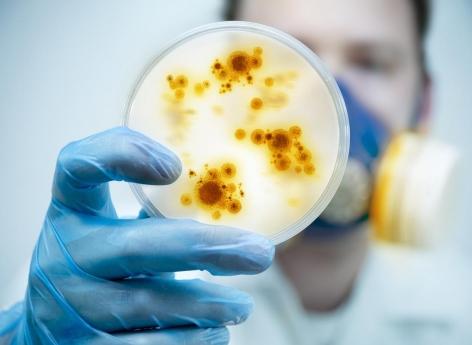

Trente minutes. C’est le temps que mettra un nouveau dispositif pour détecter la présence de bactéries dans les médicaments prescrits pour soigner les infections. Développé au laboratoire de l’université d’État de Pennsylvanie par le professeur d’ingénierie biomédicale et mécanique Pak Kin Wong, ce nouvel outil est présenté dans la revue scientifique Proceedings of the National Academy of Sciences.
L’objectif de ce nouvel outil consiste à piéger les cellules bactériennes individuelles qui pourront ensuite être observées à l'aide d'un microscope électronique. Actuellement, la technique réalisée en laboratoire qui permet d'étudier la présence et la résistance de bactéries à certains médicaments nécessite un délai de trois à cinq jours avant l'obtention des résultats.
Espoir de mise sur le marché d'ici 3 ans
L'intérêt de cette nouvelle méthode est donc d'éviter aux médecins de prescrire des antibiotiques à leurs patients pour soigner des infections, sans savoir si les bactéries présentes dans les traitements y résisteront ou non.
"Nous prescrivons actuellement des antibiotiques même sans bactérie présente. C'est de la surprescription. Plus de 75 % des échantillons d'urine envoyés à un laboratoire de microbiologie clinique sont négatifs. Le fait d'écarter ou de confirmer rapidement la présence de bactéries à une concentration cliniquement pertinente améliorera considérablement les soins aux patients", estime le Pr Wong.
Les scientifiques à l'origine de ces travaux indiquent qu'en plus de pouvoir détecter la présence de bactéries, l'appareil pourrait aider à classifier le type en déterminant si les cellules sont sphériques, en forme de tige ou en spirale. L'équipe du Pr Wong a déposé une demande de brevet provisoire et espère pouvoir commercialiser son outil d'ici 3 ans, afin qu'il puisse être utilisé dans les hôpitaux et les cabinets médicaux.